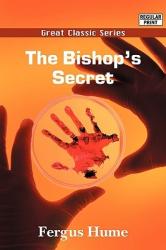

Better the Blood

A DETECTIVE IN SEARCH OF THE TRUTH
Hana Westerman is a tenacious Ma¯ori detective juggling single motherhood and the pressures of her career in Auckland’s Central Investigation Branch. When she’s led to a crime scene by a mysterious video, she discovers a man hanging in a...Read more